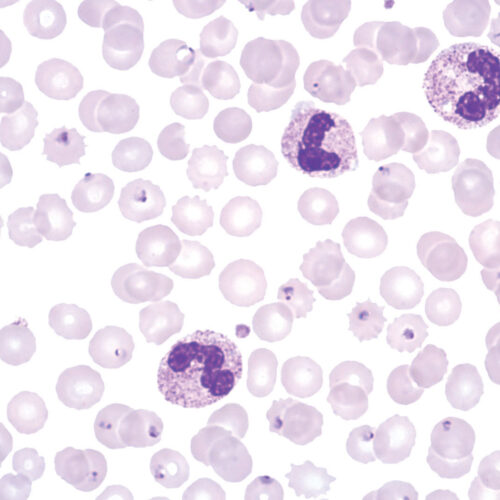

Additional staining solutions for hematology and cytology
-
Histology and cytology/Citology and hematology staining reagents/Rapid and standard hematology reagents and kits/Additional staining solutions for hematology and cytology
Brilliant Cresyl Blue, solution
Solution for staining reticulocytes in blood.
-
Histology and cytology/Citology and hematology staining reagents/Rapid and standard hematology reagents and kits/Additional staining solutions for hematology and cytology
Field kit
Ready to use two-reagent kit for rapid and efficient staining and detection of parasites in hematology samples. Primarily used for staining thin and thick blood smears (dense drop) for purpose of diagnosing blood parasites. Reagents are stored in containers that can be used as staining jars.
-
Histology and cytology/Citology and hematology staining reagents/Rapid and standard hematology reagents and kits/Additional staining solutions for hematology and cytology
Hayem’s solution
Solution for manual counting of erythrocytes.
-
Histology and cytology/Citology and hematology staining reagents/Rapid and standard hematology reagents and kits/Additional staining solutions for hematology and cytology
Leishman´s solution
Polychromatic solution of Eosin Y, Methylene Blue and azure dyes. For staining in hematology and clinical cytology.
-
Histology and cytology/Citology and hematology staining reagents/Rapid and standard hematology reagents and kits/Additional staining solutions for hematology and cytology
ThromboGnost solution
Solution for manual counting of thrombocytes.
-
Histology and cytology/Citology and hematology staining reagents/Rapid and standard hematology reagents and kits/Additional staining solutions for hematology and cytology
Tuerk’s solution
Solution for manual counting of leukocytes.
-
Histology and cytology/Citology and hematology staining reagents/Rapid and standard hematology reagents and kits/Additional staining solutions for hematology and cytology
Wright’s solution
Polychromatic solution of Eosin Y, Methylene Blue and azure dyes. For staining in hematology, cytology and cytogenetics.
-
Histology and cytology/Citology and hematology staining reagents/Rapid and standard hematology reagents and kits/Additional staining solutions for hematology and cytology
Wright-Giemsa solution
Polychromatic solution of Eosin Y, Methylene Blue and azure dyes. Modified Romanowsky stain for hematology staining.